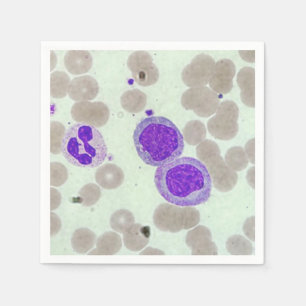
rbcs wbcs slide lab microscope hematology napkin

Peace Love Hematology T-Shirt
Price£31.30
Peace Love Hematology Latte Mug
Price£20.57
Peace Love Hematology Travel Mug
Price£24.50
Peace Love Phlebotomy Travel Mug
Price£24.50
Peace Love Phlebotomy T-Shirt
Price£25.85
Peace Love Hematology Poster
Price£15.70
hematology technician, awesome coffee mug
Price£12.65
Peace Love Hematology 6 Cm Round Badge
Price£3.75
hematology. business card
Sale Price £22.26. Original Price £31.80.
Hematology, RBC, WBC Wrist Watch
Price£54.60
Lab Queen - Laboratory Girl Mug
Price£15.15
Hematology Nurse T-Shirt
Price£35.20
I Love Hematology Blood Cell Lineage Apron
Price£28.75
I Love Hematology Blood Cell Lineage Cushion
Price£40.65
I Love Hematology (Blood Cell Lineage)
Price£1.42
I Love Hematology Blood Cell Lineage Planner
Price£37.55
Hematology, RBC, WBC Clock
Price£43.70
RN Hematology Oncology T-Shirt
Price£27.50
The Zazzle Promise
Love It Guarantee
Don't love it? We'll take it back! 30-day returns “100% Love It Guarantee.”
Easy International Delivery
Hassle-free shipping with no surprise fees. We cover any customs & duties.
Secure Shopping Guaranteed
100% Secure payment with SSL Encryption.
Search Feedback
If you need help or have a question for Customer Service, please visit our Help Centre
Recently Viewed Items